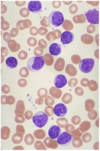

Leukemia Flashcards
(59 cards)
Leukemias are neoplasms of ____
hematopoietic cells
Leukemias have significant ____ and ____ involvement
peripheral blood and bone marrow
What is seen in this image?

This is a normal bone marrow biopsy
See normal architecture
See mixture of cell types
Appropriate amount of fat cells
What does the presence of a CD34 marker tell you?
This means the cell is IMMATURE!
These are present on hematopoietic stem cells
T cells have WHAT CD markers?
Low numbers!
CD 1, 2, 3, 4, 5, 7, 8
CD 13:
Mid-teens = Myelomonocytic
CD 13 = granulocyte
(GMG = 13, 14, 15)
CD 14:
Mid-teens = Myelomonocytic
CD 14 = monocytic
(GMG = 13, 14, 15)
CD 15:
Mid-teens = Myelomonocytic
CD 15 = granulocyte
(GMG = 13, 14, 15)
B cells are characterised by what CD markers?
CD 19, 20, 21, 22, 23
CD 33:
myeloid marker
Co-expression of CD5 and CD20:
Indicates CLL - this is not a normal finding!!!
Immunophenotyping:
Identifying the phenotype using fluorexcently labeled antibodies (probe)
CML is a ______ disorder (as are P vera, ET, and primary myelofibrosis)
myeloproliferative disorder
Describe the cell types generated/found in CML:
Hit occurs at hematopoietic stem cell
Cells maintain the ability to differentiate
Morphologically heterogenous population of cells at all levels of myeloid differentiation.
Common symptoms, physical exam findings, and lab findings of CML patients:
Common symptoms:
- Fatigue, sweats, fevers
- Weight loss/anorexia
- Abdominal fullness, early satiety
Physical exam findings:
- Splenomegaly
- Hepatomegaly
Common laboratory findings:
- Leukocytosis (neutrophilia, basophilia, eosinophilia)
- Anemia
- Thrombocytosis
20-40% of patients are asymptomatic!
Peripheral blood smear and bone marrow findings of CML patients:
Peripheral blood:
- numerous immature granulocytes
- Increased basophils
Bone marrow:
- hypercellular
- Increase M:E
Is this bone marrow biopsy normal?
What disease is suspected?

This is abnormal
See a bunch of maturing granulocytes, with almost no fat at all.
CML
t(9;22) is characteristic of WHAT disease processes?
t(9;22) is the Philadelphia chromosome, which is present in 95% of CML cases.
Can also be found in ALL, where it has a super bad prognosis
t(9;22) fuses what genes? What is the functional result?
Fuses BCR and ABL
ABL is a tyrosine kinase signal transducer - this fusion promotes constitutive cell signaling.
What is the best screening test for CML?
FISH
What is a CML blast crisis?
This occurs when the disease is left untreated, and cells gain additional genomic hits. This results in the formation of an acute leukemia, characterized by constitutional symptoms, complications of cytopenias, extramedullary disease, etc.
Median survival: 3-6 months
What are the treatment options for CML? What are the outcomes?
First line treatment - ABL tyrosine kinase inhibitors (such as Imatinib aka Gleevec). These work super well.
Could also consider allogenic stem cell transplant
CLL (chronic lymphocytic leukemia) is a malignancy of _____
mature B cells
In CLL, the malignant cells are a morphologically _______ population of ______
In CLL, the malignant cells are a morphologically homogenous population of mature lymphocytes